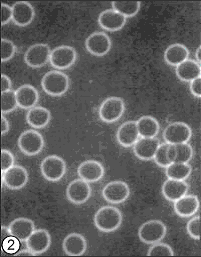
megahydrate-clustered-cells-2

Did you know that researchers estimate that half of the world’s population is chronically dehydrated? And in America, that level rises to 75 percent of the population. These are very eye-opening statistics when we consider that so many people are sipping on sodas, tea and coffee all day long. Even though most people know perfectly well that water provides the best hydration to the body, most fall short of the 10 daily cups prescribed by the Institute of Medicine. In medical terms, most people in the USA function daily in a chronic state of dehydration. Dehydration impairs your ability to think, drive, and perform crucial tasks. Without the adequate hydration that pure and clean water provides, your body’s biochemical and electrical processes can quickly begin to break down. This is why we need to talk about the many health benefits of MegaHydrate.
MegaHydrate – Are You Dehydrated?
Dehydration is one of the most frequent causes of hospitalization for people over 65. With age, many confuse thirst with hunger causing overeating and thus more dehydration. Those that are highest risk of dehydration are: outside workers exposed to high heat; seniors, people with chronic illness; athletes; infants and young children and people who live in high altitudes.
Why do people lack hydration? This may be due to several things such as a poor thirst mechanism as we age, dissatisfaction with the taste of water, the over consumption of caffeine and alcohol, climate controlled environments (both heated and air-conditioned), and even excessive exercise. With water loss at 2% of body weight, individuals can experience impaired physiological and mental performance. Drinks that worsen dehydration include soda, very sweet drinks and caffeinated drinks.
Know the Signs of Dehydration
The signs and symptoms of dehydration range from minor to severe.
- Increased thirst
- Dry sticky mouth and swollen tongue
- Weakness
- Dizziness
- Palpitations (feeling that the heart is jumping or pounding)
- Confusion – especially in the elderly
- Sluggishness, even fainting
- Sleepiness or tiredness — children are kess active than usual
- Few or no tears when crying
- Inability to sweat
- Constipation
- Headaches
- Decreased urine output: Urine color may indicate dehydration. If urine is concentrated and deeply yellow or amber, you may be dehydrated.
MegaHydrate – Ultimate Hydration
What is MegaHydrate?
A leading edge food-grade dietary supplement, MegaHydrate that is rich in antioxidants and provides ultimate hydration. When taken with water, it delivers billions of negatively charged Hydrogen ions to the cells of the body. MegaHydrate provides a way to boost cellular hydration by reducing the surface tension of water within the body which makes the water in and between our cells hydrated. The concept is that with excellent hydration and surface tension of this fluid, the body has the ability to more efficiently eliminate toxins and metabolic by-products on the most basic level. In addition, a potential increase in the delivery of important nutrients happens which grants healthier cells and a healthier body.
More than one hundred times stronger than popular plant-based antioxidant sources such as Vitamin E, Vitamin C, green tea extract, and grape seed extract, MegaHydrate has been tested in a clinical setting for its relevance to all-inclusive well-being and free-radical elimination. According to the creator of MegaHydrate, physicist and medical doctor, Patrick Flanagan, silica hydride is the only antioxidant compound that does not convert itself into a pro-oxidant after donating its electrons, instead of combining with other hydrogen atoms to form a harmless gas or with oxygen and hydrogen to form water.
MegaHydrate is safe, and tests show that is has no known side effects other than mild detoxification symptoms for some people.
The silica hydride in MegaHydrate is a compound known to positively affect the “zeta potential” of blood cells. Zeta potential (x) is the electric potential, or charge, that exists in a hydrated particle and the surrounding solution. Zeta potential is an important and useful indicator in which this charge can be used to predict and control the stability of colloidal suspensions. The greater the zeta potential, the more likely the suspension will be stable because the charged particles repel one another and thus overcome the natural tendency to aggregate.
Zeta potential is an electrical charge that describes how far apart cells are. Greater zeta potential indicates more space between cells. Increased zeta potential has many positive health benefits. More zeta potential means more surface area for cells. Toxins, viral matter, fungi, and bacteria trapped between cells can be expunged more readily. More importantly, water enters cells more easily. Water is arguably the most vital component of anti-aging, life extension, and the removal of free radicals and waste.
The following test was performed and replicated by several groups of scientists with the same results. It provides yet more data indicating that MegaHydrate is a contributor to good health.

PHOTO 1 shows a microscopic view of a blood sample from a subject with low zeta potential. The blood cells are clustered together and trap waste elements between them. Note the clustering effect may be a result of dehydration from caffeine, alcohol, heat, and stress: all commonly found in people today.
The test subject was given 500 mg (or two 250 mg capsules) of Silica Hydride – the active ingredient in MegaHydrate – mixed with 8 oz of water.
Twenty minutes later, another blood sample taken from the test subject was viewed under a microscope (as seen in PHOTO 2). The evenly-dispersed blood cells indicates high zeta potential. The blood cells appear pristine, as if the substances trapped between the cells have been cleansed. The surface area of the cells has increased allowing exponentially more nutrients into the cells and more toxins to be removed. MegaHydrate’s Silica Hydride is the only known supplement to dramatically increase zeta potential.
MegaHydrate – Powerful Antioxidant
What are anti-oxidants?
Antioxidants are key contributor to healthy and longevity.
“The antioxidant network: Keeps your body youthful; Bolsters your natural defenses against cancer; Prevents and even reverses heart disease; Sharpens your mental edge… Long term use of antioxidants is recommended. This is not a ‘quick fix’ but part of a lifestyle change: a commitment with a perseverant attitude toward safeguarding and enhancing your system.”
James Balch, M.D. – Author of “The Super Anti-Oxidants” and “Prescription for Nutritional Healing”
Comparing the effectiveness of the Silica Hydride in MegaHydrate on free radicals versus other natural, and even synthetic, antioxidant compounds clearly shows that Silica Hydride is 800% more effective than other known products or foods.

One daily dose of MegaHydrate has more antioxidant power than hundreds of glasses of fresh vegetable and fruit juices, broccoli, Brussel sprouts, leafy greens, and other foods rich in antioxidants to prevent free radical damage.
MegaHydrate provides natural pain relief from headaches, sore muscles, and inflammation of the joints. Studies show that MegaHydrate increases energy production (adenosine triphosphate or ATP) by up to 4 times. People with fibromyalgia and other conditions associated with energy production and hydration usually find substantial pain relief.
MegaHydrate – Anti-Aging
Humans must have Hydrogen to survive. It is the key to long life and anti-aging. However, due to mass food production, mineral deficient soil, pesticides, chemical fertilizers, over-processing of foods, chemical preservatives, and drinking over-chlorinated and over-fluoridated water, people do not get enough Hydrogen ions daily. Body cells become damaged, hydration levels decrease and cells age. In summary, MegaHydrate challenges the symptoms of dehydration and minimizes the process of aging. Many people also report increases in energy.
MegaHydrate also is the key that unlocks the potential of water as the medium for nutrient replenishment and waste removal at the cellular level.
Many people ask me about what anti-aging strategies they can use. MegaHydrate is always one of the first products I recommend. When you are sufficiently hydrated, your skin looks younger, wrinkles are not as pronounced and your energy levels will be high. All of these are very noticeable anti-aging properties from just the simple task of keeping your body hydrated!
MegaHydrate Health Benefits
- Contains Hydrating Silica Microclusters®
- Powerful Antioxidant
- Recycles other key antioxidants in the body
- Safe and Non-Toxic – No known side effects
- Increases the Production of Cellular ATP
- Reduces Pain & Inflammation
- May Slow the Aging Process
- Neutralizes Harmful Toxins like Fluoride, Chlorine, etc.
- Increases Absorption of other Supplements
- Lowers Surface Tension of Water You Drink Leading to Improved Detoxification
- Removes Heavy Metals from the Body
- Increase Zeta Potential of Human Cells
- Increases Cellular Hydration
- Provides Negatively Charged Hydrogen Ions
- Provides Oxygen
- Protects Telomeres by allowing cells to exceed the Hayflick limit by 4-5 times
- Protects and Repairs DNA
- Protects Against and Repairs Radiation Damage
Information & Research
1. Journal of Medicinal Food – Volume 5, Issue Number 1, 2002. Antioxidant Capability and Efficacy of Mega-H-™ Silica Hydride, an Antioxidant Dietary Supplement, by In Vitro Cellular Analysis Using Photosensitization and Fluorescence Detection. (click to download)
2. International Journal of Hydrogen Energy – Volume 28, Issue 11, 2003. Synthesis of a Novel Anionic Hydride Organosiloxane Presenting Biochemical Properties. (click to download)
3. International Journal of Hydrogen Energy – Volume 29, Issue 5, 2004. Non-Toxic Hydride Energy Source for Biochemical and Industrial Venues: ORP and NAD+ reduction analyses. (click to download)
4. Journal of Medicinal Food- Volume 6, Issue Number 3, 2003. Evaluation of Hydroxyl Radical-Scavenging Abilities of Silica Hydride, an Antioxidant Compound, by a Fe+2-EDTA Induced 2-Hydroxyterephthalate Fluorometric Analysis. (click to download)
5. Free Radical Biology and Medicine – Volume 35, Issue 9, 2003. Antioxidant Capacity of Silica Hydride: a Combinatorial Photosensitization and Fluorescence Detection Assay. (click to download)
6. Journal of Medicinal Food- Volume 7, Issue Number 1, 2004. Differential Metabolic Effects on Mitochondria by Silica Hydride Using Capillary Electrophoresis. (click to download)
7. Molecular Hydrogen Foundation (MHF)
The references below are a condensed bibliography of studies related to Silica Hydride and Microcluster research.
Brooks GA, Brown MA, Butz CE, Sicurello JP, Dubouchaud H. Cardiac and skeletal muscle mitochondria have a monocarboxylate transporter MCT1. Journal of Applied Physiology 87(5): 1713-1718, 1999.
Carlisle EM. A silicon requirement for normal skull formation in chicks. J Nutr 1980,110;352-9. Carlisle EM. In vivo requirement for silicon in articular cartilage and connective tissue formation in the chick. J Nutr 1976, 106;4:478-84.
Castleman AW. Invited Article. The Journal of Physical Chemistry 1996, Centennial Issue, 100: 12911-12944.
Degani Y, Willner I. Photoinduced hydrogen evolution by an electron acceptor. The functions of SiO2 colloid in controlling the electron-transfer process. J. Am. Chem. Soc. 105: 6228-6233,1983.
Dove PM, Rimstidt JD. Silica-water interactions. In Heany PJ, Prewkt CT, Gibbs GV, (eds): Silica, Physical Behavior, Geochemistry, and Materials Application. Reviews in Mineralogy 29:259-301,1994.
Flanagan P, Purdy Lloyd K. A silicate mineral supplement, Microhydrin®, traps reduced hydrogen providing in vitro biological antioxidant properties. Proceedings National Hydrogen Association 1999,10;595-610.
Gascoyne PRC, Pethic R, Szent Gyorgyi A. Water structure-dependent charge transport in proteins. Proc Nad Acad Sci USA 1981,78; 1:261-265.
Gross ML, Aerni RJ. The unusual loss of hydrogen from ionized 1,5- Hexadiyne. J Am Chem Soc 1973,95;23:7875-7877.
Happe RP, Rosebloom W, Pierik AJ, Albracht SPJ, Bagley KA. Biological activation of hydrogen. Nature 1997,385; 126. Hayashi H. Water the chemistry of life, part IV Explore 6, 1995: 28-31.
Hoffer EC, Meador CK, Simpson DC. Correlation of whole body impedance with total body water volume. J App Phys 1969;27:531.
Hopkins FG, Morgan EJ. Biochem J 1948, 42; 23-27. Hopkins FG. Biochem J 1925, 19;787.
Hopps HC. Geochemical environment related to health and disease. Geological Society of America Special Paper 155:1-9,1975.
Jaqmin Godda H, Commenges D, Letenneur L, Dartigues JF. Silica and aluminum in drinking water and cognitive impairment in the elderly. Epidemiology 7:281- 285,1996.
Keller WD, Balgord WD, Reesman AL. Dissolved products of artificially pulverized silicate minerals and rocks: part I. Journal of Sedimentary Petrology 33:191- 204,1963.
Keller WD, Feder GL. Chemical analysis of water used in Hunza, Pakistan. In Hemphill D.D. (ed): “Trace Substances in Environmental Health-XIII, Proceedings.” University of Missouri-Columbia: 130-137,1979.
Keller WD, Reesman AL. Glacial milks and their laboratory-simulated counterparts. Geol Soc Am Bull 74:61-76,1963. Keller WD. Argillation and direct bauxitization in terms of concentrations of hydrogen and metal ions at surface of hydrolyzing aluminum silicates.
Bulletin of the American Association of Petroleum Geologists 42:233-245,1958. Keller WD. Drinking Water: A geochemical factor in human health. Geological Society of America Bulletin 89:334-336,1978.
Kleiner SM. Water: An essential but overlooked nutrient- J American Dietetic Association 1999,99;2:200-206.
Klotz IM, Ayers, J, Ho JYQ Horowitz MG, Heiney RE. Interactions of proteins with disulfide compounds: some implications for electron transport in proteins. J Am Chem Soc 1958,80;2132-2141.
Klotz IM. Protein hydration and behavior. Many aspects of protein behavior can be interpreted in terms of frozen water of hydration. Science 1958,10;815-821.
Langmuir, Irving. Flames of Atomic Hydrogen. Industrial and Engineering Chemistry 1927, June,19:8; 607-674. Leaf A. Getting Old. Scientific American 229:44-52, 1973.
Leninger AL, Nelson DL, Cox MM, (eds.): Principles of Bioenecgetics. In”Principles of Biochemistry” 2nd ed. New York, Worth Publishers, 1993.
Leung K.N. Bacal M. “H- ion density measurement in a tandem multicusp discharge.” Rev Sci Instrum 1984, 55; 3; 338-341.
Mackor EL, van der Waals J.H. The statistics of the adsorption of rod-shaped molecules in connection with the stability of certain colloidal dispersions, j Colloid and Interface Science 1952,6;535-550.
Marlow, Bruce. Privately funded research monograph entitled: Electrophoretic Fingerprinting of Silica Concrete Treatment Solution, 1993. MaughTH. Soviet science: A wonder water from Kazakhstan. Science 1978, 202; 414.
Meusinger J, Corma A. Influences of Zeolite composition and structure on hydrogen transfer reactions from hydrocarbons and from hydrogen. Journal of Catalysis 1996,159;2:353-360.
Morell, Franz. An Official Transcript of the three hour lecture and slide presentation by Dr. Franz Morel of West Germany regarding “The Bio-Electronic Method of Professor Vincent”, as given at the O.I.C.S. Alumni Associations German Electro-Acupuncture Week in July, 1982 at El Rancho Inn, Millbrae, California, U.S A .
Mukherjee JN, Chatterjee B, Ray A. Liberation of H+, Al+++ and Fe+++ ions from pure clay minerals on repeated salt treatment and desaturations. Colloid Science May 1948, 437-445.
†Results may vary. Information and statements made are for education purposes and are not intended to replace the advice of your doctor. Oasis Advanced Wellness/OAWHealth does not dispense medical advice, prescribe, or diagnose illness. The views and nutritional advice expressed by Oasis Advanced Wellness/OAWHealth are not intended to be a substitute for conventional medical service. If you have a severe medical condition or health concern, see your physician of choice.






